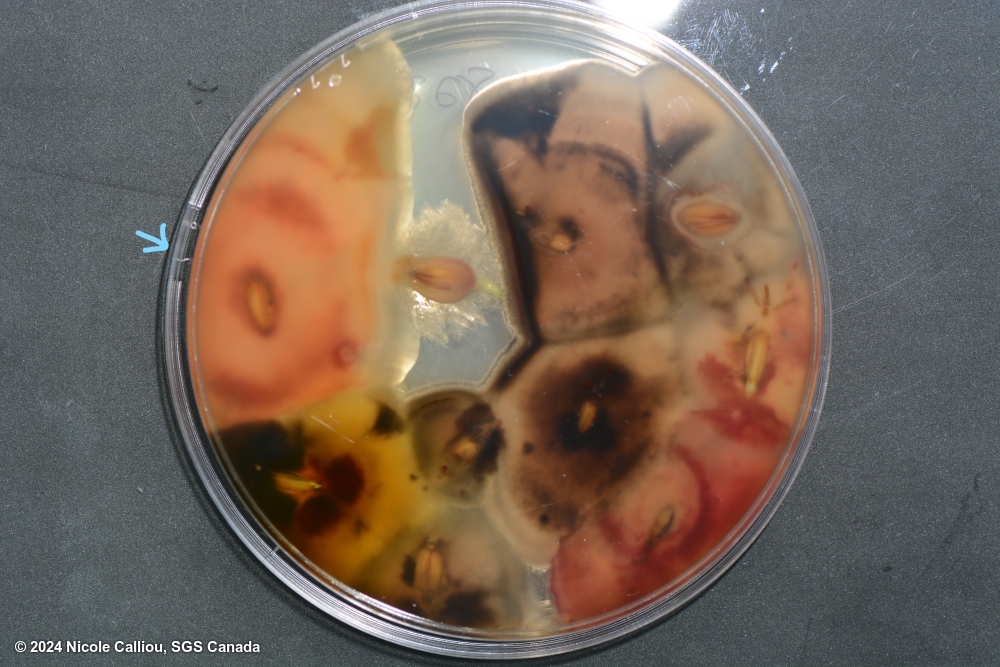

Fusarium poae
Overview
|
Scientific name
|
Fusarium poae |
|
Genus
|
Fusarium |
|
EPPO code
|
FUSAPO |
|
Common name
|
Root rot of grasses |
|
Synonyms
|
Sporotrichum poae |
Description
On PDA, growth is very rapid, with dense aerial, cotton like mycelium, often described as hairy or felted, and changing to powdery as microconidia are formed. Mycelium is generally white in colour, but can be yellow or pale pink, often becoming darker with age. Spores are readily formed in the mycelium. The under surface is usually pink to red, but colour variation including yellows can be observed. Sporodochia are rare.
On malt agar, the mycelium is dense, aerial, white to pink. Sporodochia are rare.
Regardless of agar type, colonies will produce a very distinct scent, generally described as sweet. Often compared to apples or strawberries.
Conidiophores: Unbranched and branched monophialides. Microconidiophores are short and fat, almost globose, and quite distinctive.
Macroconidia are generally rare, typically sickle shaped, 3-5 septate, but usually 3-septate. They will have a foot shaped basal cell.
Microconidia are extremely abundant, globose, or oval in shape (napiform), sometimes with a distinct papilla, and usually 0- but sometimes 1-septate.
Chlamydospores occur infrequently and may be in clumps or chains.